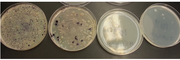
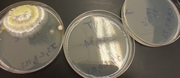

Uploads by Ji Won Shin
From OpenWetWare
Jump to navigationJump to search
This special page shows all uploaded files.
| Date | Name | Thumbnail | Size | Description |
|---|---|---|---|---|
| 20:08, 22 March 2014 | Egg 2.PNG (file) |  |
54 KB | |
| 02:02, 17 March 2014 | DNA-B.PNG (file) |  |
139 KB | |
| 03:22, 1 March 2014 | Food web 1.png (file) |  |
836 KB | |
| 02:53, 1 March 2014 | Worms.PNG (file) |  |
242 KB | |
| 01:55, 1 March 2014 | Vertebrates.PNG (file) |  |
536 KB | |
| 17:52, 26 February 2014 | Table 1- Invertebrates.png (file) |  |
248 KB | |
| 04:58, 26 February 2014 | DNAPCR.PNG (file) |  |
125 KB | |
| 04:54, 26 February 2014 | Monocot.PNG (file) |  |
43 KB | |
| 04:37, 26 February 2014 | Transect Samples.PNG (file) |  |
353 KB | |
| 03:12, 26 February 2014 | Arthropods.PNG (file) | 12 KB | ||
| 03:12, 26 February 2014 | Transect.PNG (file) |  |
960 KB | |
| 00:41, 17 February 2014 | Bacteria Cell Morphology Observations.PNG (file) |  |
122 KB | Reverted to version as of 00:38, 17 February 2014 |
| 18:31, 16 February 2014 | 100-fold Serial Dilutions Results.PNG (file) | 11 KB | ||
| 18:30, 16 February 2014 | 100-fold Serial Dilutions Results..PNG (file) | 11 KB | ||
| 17:10, 16 February 2014 | Fusiliurm Spirilum.PNG (file) |  |
33 KB | |
| 17:00, 16 February 2014 | White Swab.PNG (file) |  |
3 KB | |
| 17:00, 16 February 2014 | White Big Swab.PNG (file) |  |
21 KB | |
| 16:59, 16 February 2014 | Plates without tetra.jpg (file) | |
205 KB | |
| 16:58, 16 February 2014 | Plates with Tetra.jpg (file) | |
256 KB | |
| 16:58, 16 February 2014 | Purple Swab.PNG (file) |  |
10 KB | |
| 01:03, 10 February 2014 | Sample 1-3.jpg (file) |  |
282 KB | |
| 21:38, 9 February 2014 | Hay Infusion Midde.jpg (file) |  |
321 KB | |
| 21:36, 9 February 2014 | Hay Infusion Middle.jpg (file) |  |
321 KB | |
| 21:36, 9 February 2014 | Hay Infusion Very Top.jpg (file) |  |
382 KB | |
| 21:35, 9 February 2014 | Hay Infusion Bottom.jpg (file) |  |
332 KB |